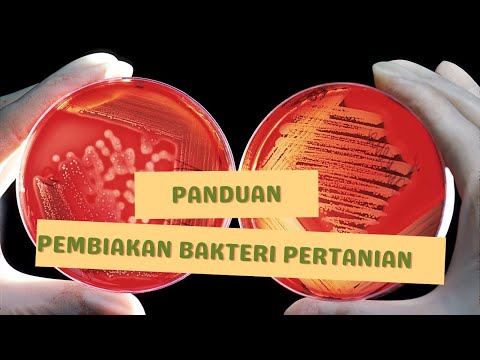

Download Lahan Bakteri Songs - MP3 & MP4
Free Lahan Bakteri Downloads
Discover and download Lahan Bakteri songs in high quality MP3 and MP4 formats. Click on any song title below to access the download page with multiple quality options.
Search Results for "Lahan Bakteri"
MP3 & MP4
Tahap ke 5,Cara Sterilisasi Lahan Pertanian/pengolahan lahan yg endemik layu pd tanaman
MENU TANAMAN


BANG REMI LEAKS THIS SECRET..‼️ BACTERIA AND HUMIC ACID TO FERTILIZE THE SOIL #2
CeritaTani

STERILISASI LAHAN BEKAS LAYU FUSARIUM, LAYU BAKTERI, BUSUK BATANG, MUDAH & AMPUH..!!!
BELAJAR BERTANI - 77


CARA APLIKASI BAKTERI MIKROBA IMO PUPUK ORGANIK CAIR PADA TANAMAN CABE 48 HST SUBUR BERBUAH LEBAT
Baraya Tani TV

SUBURKAN TANAH PERTANIANMU DENGAN 4 BAKTERI PELARUT FOSFAT INI ❗❗❗
Penyuluh Pertanian Lapangan

Mengatasi Layu Bakteri dan Layu Fusarium Pada Tanaman Kentang | Umur 70 HST Rentan Layu
LAHAN PINTAR


POWERFUL!!! Grass Root Microbes. Sprayed with Poison Many Times, But the Grass Never Dies.
Ali Maskur Hadi

TUTORIAL PALING LENGKAP | CARA MEMBUAT BAKTERI IMO DARI AWAL SAMAI DENGAN CARA APLIKASI PADA TANAMAN
Baraya Tani TV


Cara Praktis Mencegah Bakteri Dan Jamur pada Lahan Sawah Sebelum Ditanami Padi
Lahan Organik

Bakteri Terkuat Pada Alam yang Mampu Membenah Tanah ‼️ Selama Ini Salah Kaprah 😩 | UPLAND Project
Nofrizal Official
18
Songs Found
HD
Quality
Free
Downloads
Fast
Speed
About MetroLagu
MetroLagu is the best site for downloading music and videos online. We provide high-quality MP3 and MP4 downloads for free.
Features:
- High Quality Audio
- HD Video Downloads
- Mobile Friendly
- Fast Downloads